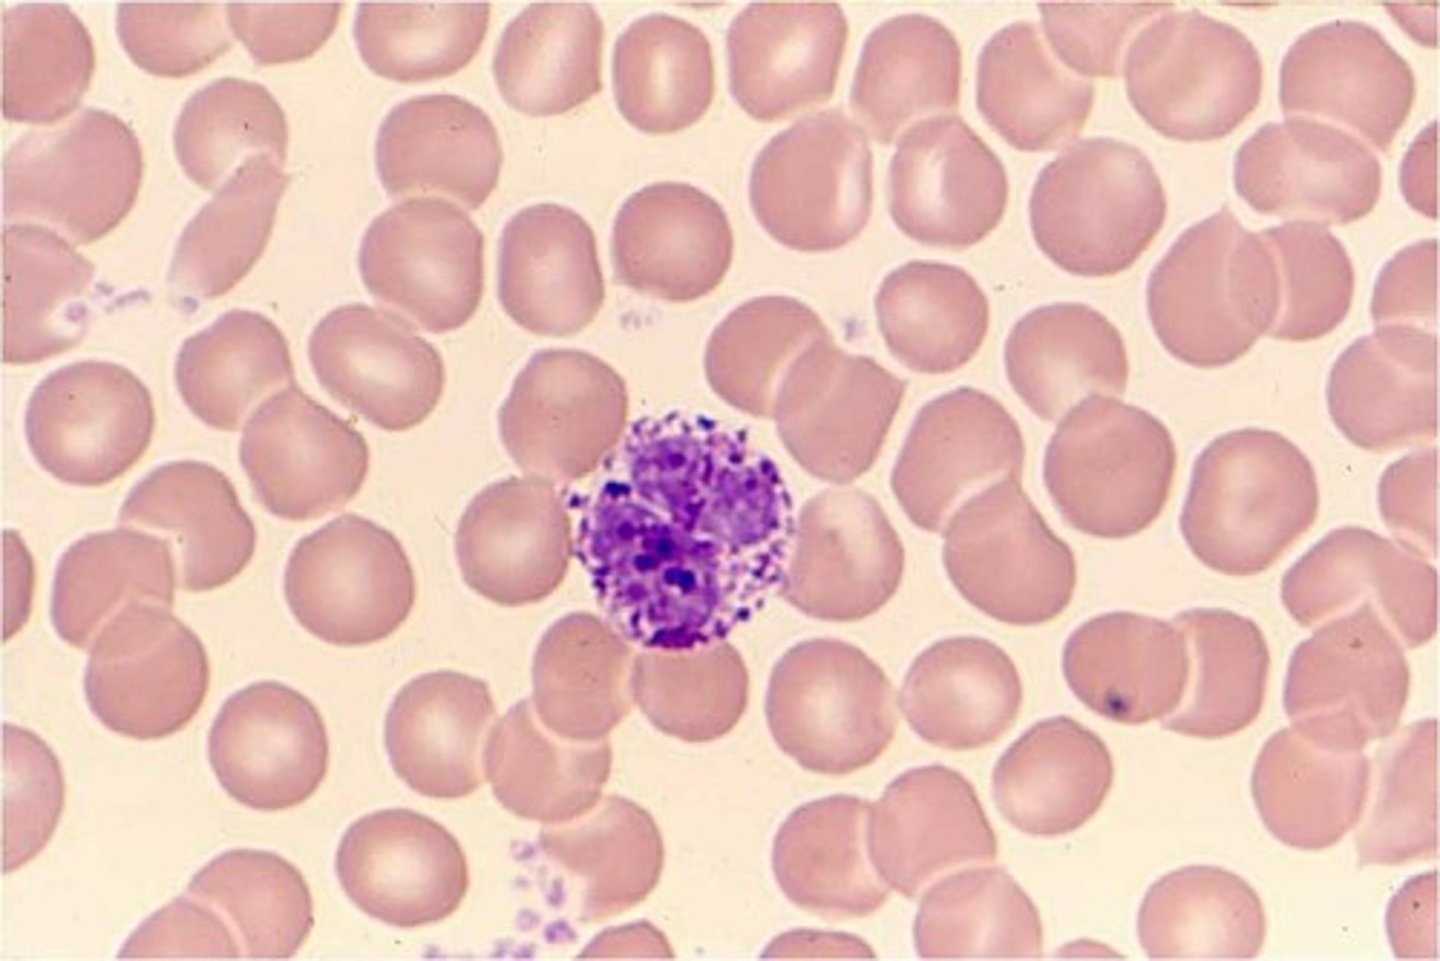
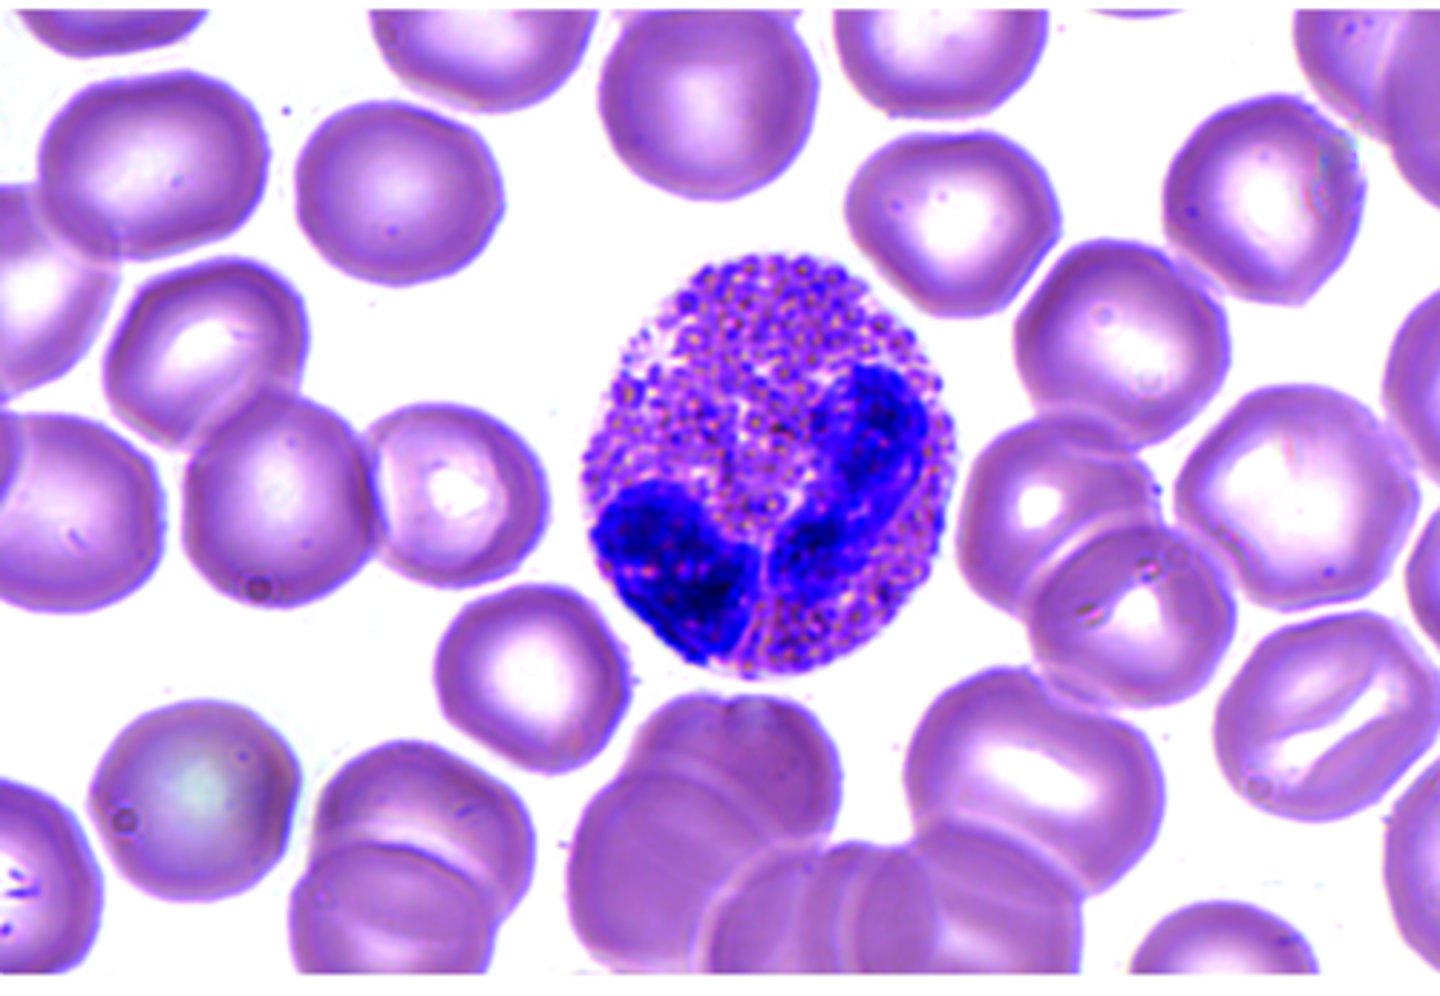

1/128
Looks like no tags are added yet.
Name | Mastery | Learn | Test | Matching | Spaced | Call with Kai |
|---|
No study sessions yet.
Histology
microscopic study of tissues
biopsy
removal of tissue for diagnostic purposes

autopsy
examination of organs of a dead body to determine cause of death

epithelial, connective, muscle, nervous
what are the 4 types of tissue

epithelial tissue
-little extracellular matrix
-covers/lines body surface
-free border
-basement membrane attaches it to underlying tissue
-avascular: gases/nutrients must diffuse across basement membrane
classification
what is based upon number of cell layers and cell shape?
simple
what is monolayer?
stratified
what is multilayers?

pseudostratified
what is false appearance of being multilayered, but each cell is in contact with the basement membrane?

squamous
what is "flat?'

cuboidal
what is "boxlike?"

columnar
what is "tall, narrow?"

functions of epithelial tissue
-protecting (lining the mouth)
-barriers (skin)
-passages of substances (nephron of kidney)
-secreting (pancreas)
-absorbing (lining of small intestine)
stratified squamous epithelium
what may be moist (mouth, esophagus, vagina, rectum) or keratinized- outer cells dead and contain tough, moisture-resistant protein = keratin?

transitional epithelium
what is stratified, stretches without tearing?
-cell layers slide past one another (urinary bladder)

diffusion(lungs), secretion(glands), filtration(glomerulus), absorption(intestines)
what are the functions of something that is "simple?"
protection/barrier function, found in areas where abrasion occurs
what are the functions of something that is "stratified?"
thin/flat = secretion or absorption
what are the functions of something that is "squamous?"
secretion or absorption
what are the functions of something that is "cuboidal &/or columnar?"
goblet cells
what produces mucus (intestinal track)?

microvilli
what increases surface area (brush border of small intestines)

cilia
what created a directed movement across the cell membrane (trachea, nasal cavity)

folds
what is something that helps organs be able to change shape?

stereocilia
what are elongated microvilli that are used for sensation and absorption called?

cell connections
what mechanically binds cells together?

permeability barrier
what type of barrier do cell connections create?

permit intercellular communication
what type of communication do cell connections have?
glycoprotein
what do epithelial cells produce that connects cells to each other and to the basement membrane?

lateral and basal surface of cells
where are cell connections found?

desmosomes
what are disk-shaped structures with sticky glycoproteins? these reinforce cell-cell connections at stress point.

hemidesmosomes
what attaches epithelial cells to the basement membrane? (half of desmosomes)

tight junctions
what forms a permeability barrier? This is made so materials can't pass between cells but must pass through the cells instead.

zona adherens
what is the girdle of glycoproteins? it binds cells together.

zona occludens
what is the ring around cells?

gap junctions
what is a small protein channel that allows small polar materials to pass between cells? it is an important coordinating function (intercalated disks- cardiac muscle)

glands
what have secretory functions? they are composed primarily of epithelia, and they are the supporting network of connective tissue.

exocrine glands
what type of gland has ducts, and is open contact maintenance with exterior?

endocrine gland
what type of gland is ductless and produces hormones? it also has no open contact with exterior.

unicellular
goblet cell -> mucus
merocrine
what are vesicles releasing contents into ducts? It is secretion with no loss of cytoplasm. An example of this is eccrine sweat glands.

apocrine
what is the pinched off portion of the cell in secretion called? It is secretion with some loss of cytoplasm. An example of this is the mammary galnds

holocrine
what sheds into the duct? This is when the cell becomes part of the secretion. An example of this is the sebaceous gland.

multicellular
classification based on duct structure and secretion
simple
what is a duct with a few branches
compound
what is a duct with many branches call?
tubular
what is duct called that ends in straight/coil tubes?
acinar
what are ducts called that end in cluster of small sacs
alveolar
what are ducts called that end in hollow sacs?
connective tissue
what type of tissue is abundant nonliving, and has extracellular matrix?
matrix components of connective tissue
- protein fibers present
- ground substance present
- fluid present
- generally, well vascularized
these components are the matrix components of what type of tissue?
"blasts"
what are cells that build/create the matrix called (prefixes)
"cytes"
what are the cells that maintain matrix called (prefixes)
"clasts"
what are cells that breakdown/remodel the matrix called (prefixes)
collagen fibers
what are the fibers called that are strong and flexible? they don't stretch, and they are the primary protein in the body.

reticular fibers
what are the fibers called that are fine collagen fiber networks? They are between the tissue and organs.

elastin fibers
what are the fibers called that stretch and recoil? they return to their normal shape after stretching. They consist of protein elastin.

adhesive molecules
what molecules hold proteoglycan aggregates together? an example is chondronectin in cartilage.
ground substance
this contains hyaluronic acid and polysaccharides, its slippery, and acts as a lubricant.
proteoglycan- CHO + protein, traps H2O----> resiliency

fluid
all extracellular fluid associated with a tissue
CT classification
based on nature of matrix and fibers present
loose fibrous CT
collagenous fibers that are loosely arranged are called what? They are protein fibers that have fluid filled spaces, and all three types of fibers are present. This is also the most abundant CT in the body.
dense fibrous CT
fibers from thick bundles that nearly fill extracellular space?
fibrous CT
loose vs dense; based on protein fibers
regular vs irregular; based on fiber arrangement
fibroblast
what is a cell that produces fibrous matrix of CT called?

regular dense CT
what are fibers called that run in a single direction called?

collagenous tissue
what tissue is seen in tendons and ligaments?

elastic tissue
what tissue is seen in ligaments of vertebrae?

ligaments
what connects bone to bone? collagen often less compact and usually flattened.

tendons
what connects muscle to bone? fibers are not necessarily parallel.

irregular dense CT
what are fibers that run in many different directions called?

collagenous irregular CT
what CT is the reticular layer of the dermis?

elastic irregular CT
what CT is the walls of large arteries? It is bundles of collagenous and elastic fibers oriented in many directions.

adipose tissue
what are fat cells that surround lipid droplet? They are used as energy storage, insulation, and protection.

reticular tissue
what is the tissue called that is a network of fine collagen fibers that form framework of lymphoid tissue, bone marrow, and liver?

fat storage
what is yellow bone marrow do?

blood cell production (hemophoiesis)
what does red bone marrow do?

Yellow; red
as a child grows _____ marrow replaces most of the ____ marrow.
cells of connective tissue
These cells are cells in what type of tissue?
-white blood cells
-macrophages (fixed and wandering)
-platelets
-undifferentiated mesenchyme
cartilage
What has a rigid matrix? the lacunae surround chondrocytes (cartilage cells). It is avascular.

hyaline cartilage
what type of cartilage is rigid with some flexibility, and the principal cartilage of the body?
EX: costal cartilage, articular cartilage, fetal skeleton, trachea, epiphyseal plate nasal septum

fibrocartilage
what cartilage withstands great pressure (shock absorber), and is found in areas of the body where a great deal of pressure is applied?
EX: intervertebral discs, meniscus of knee, pubic symphysis
perichondrium
what is dense irregular CT that surround cartilage?

elastin cartilage
what type of cartilage is high in elastin, and most flexible type? it is embedded in proteoglycans.
EX: pina, epiglottis

mast cell
common beneath membranes; along small blood vessels; can release heparins, histamine, and proteolytic enzymes in response to energy.
matrix
what gives strength and rigidity, and allows bone to support and protect other tissues and organs?
bone
what has a solid matrix with organic and mineralized inorganic material?

inorganic matrix
hydroxyapatite crystals contain Ca/P --> rigidity

organic matrix
primarily collagen --> flexible strength

cancellous (spongy) bone
what type of bone is spicules arranged in trabecular network

compact bone
what type of bone is a dense bone with regular repeating structural units = osteon

osteon
what are the structures highlighted blue called?

canaluculi
what are the structures called that the arrows are pointing to?

lacuna with osteocyte
what are the structures called that are circled?

haversian canal
what is the structure that the arrow is pointing to called?

lamellae
what is the highlighted green area called?

blood
liquid matrix = plasma
-liquid and lacks fibers
-matrix formed by other tissues, unlike other types of CT
-moves through vessels, but the fluid and cells can move in and out of the vessels

RBC (erythrocyte)
O2/CO2 transport (red blood cell)

WBC (leukocytes)
defense (white blood cell)
platelet (thrombocytes)
blood clotting (sticky)

hemopoetic tissue
what tissue forms blood cells?